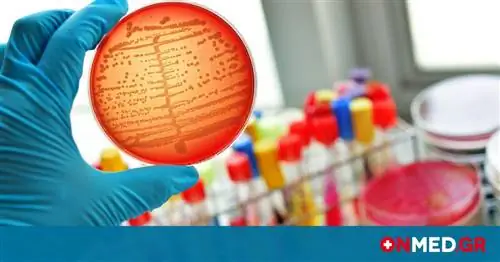

Сепсис - это серьезное осложнение инфекции, которое возникает, когда химические вещества, выделяемые в кровь для борьбы с ней, вызывают воспалительные реакции во всем организме
Эти воспаления влияют на работу органов, вызывая даже сбой, приводящий к летальному исходу.
Сепсис поражает более миллиона американцев каждый год и, по данным Национального института общей медицины, является причиной смерти не менее 500 000 человек. люди.
Сепсис может возникнуть после пневмонии, инфекции мочевого пузыря, или даже легкой травмы.
Некоторые из ее симптомов неспецифичны, поэтому пациенту может поставить неверный диагноз, что может оказаться фатальным для его жизни.
Посмотрите в следующей галерее 11 симптомов сепсиса, которые вы не должны игнорировать